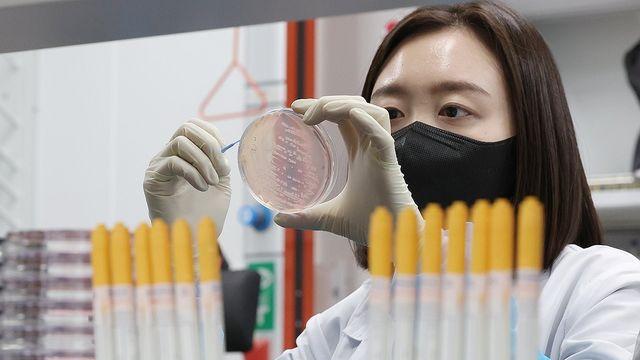
thumbimg

뉴스
- 출생연도 끝자리 '1·6', 오늘 소비쿠폰 신청…15만~45만원 지급
- 모두서치 2025.07.21
- 사진 = 뉴시스 전 국민에게 1인당 15만~45만원을 지급하는 '민생회복 소비쿠폰' 1
- 전북, 8개 시군 폭염특보 '후텁지근'…곳곳 소나기
- 모두서치 2025.07.21
- 사진 = 뉴시스 전북지역은 21일 가끔 구름 많은 가운데 후텁지근한 날씨가 이어지고,
- 강원 내륙·산지 5∼60㎜ 소나기…낮 최고 34도
- 연합뉴스 2025.07.21
- 소나기 [연합뉴스 자료사진] (춘천=연합뉴스) 강태현 기자 = 월요일인 21일 강원 내륙과
- 국토장관 후보자, 2008년 아파트 분양권 전매…"투자 목적 아냐"
- 연합뉴스 2025.07.21
- 2022년 선거서 상대 후보 분양권 전매 비판…김종양 의원 "내로남불" 장녀 아파트 전셋값
- "AI 도입 따른 기업 감원, 알려진 것보다 더 클 수 있어"
- 연합뉴스 2025.07.21
- 전문가 "기업들, 재편성 등 표현으로 'AI가 인간 대체' 사실 숨겨" AI [로이터 연합
- 울산 지역 올해 상반기 식중독 6건 발생…작년보다 50% 감소
- 연합뉴스 2025.07.21
- 식중독균 배양분리작업 시연 [연합뉴스 자료사진] (울산=연합뉴스) 김근주 기자 = 울산보건
- 건설취업자 외환위기後 최대폭 급감…생산위기→고용 '전이'
- 연합뉴스 2025.07.21
- 상반기 14만명 '뚝'…5년만에 다시 200만명 선 붕괴 건설투자 'GDP 비중' 15%
- 언더우드家 한글 공부 노트부터 '밥퍼 운동' 냄비까지 한자리
- 연합뉴스 2025.07.21
- 한국기독교역사문화관 내달 12일 개관…개신교의 빛과 그림자 함께 조명 나눔의 정신 상징하는
- 건강하게 먹으면 의료비 덜 든다…9%가량 적어
- 연합뉴스 2025.07.21
- 서울대병원 박민선 교수 연구팀, 성인 1천144명 분석 집밥 반찬 [연합뉴스TV 캡처] (
- 충북 구름 많고 오후에 소나기…낮 최고 34도
- 연합뉴스 2025.07.21
- (청주=연합뉴스) 김형우 기자 = 21일 충북은 구름이 많고 오후에 소나기가 내리는 곳이
- 복지부, 자살 유족 치유 글 모은다
- 이데일리 2025.07.21
- [이데일리 이지현 기자] 보건복지부는 21일부터 8월 20일까지 ‘2025년 자살유족 수기
- SK에코플랜트 '매출 부풀리기' 의혹…檢고발 등 중징계 기로
- 연합뉴스 2025.07.21
- 24일 감리위 거쳐 증선위서 결론…IPO 앞두고 美자회사 매출 과대인식 정황 새 정부서 대
- 대학병원 치료 후 동네 치과로 돌아가는 길 막힌 치과 환자들
- 연합뉴스 2025.07.21
- 서울대 치과병원 등 4개 국립대 치과병원 의뢰·회송 실태 첫 전수조사 "제도 부재 속 '일
- 서울시-롯데칠성음료, 북서울꿈의숲 월영지 수질개선 맞손
- 연합뉴스 2025.07.21
- 서울시-롯데칠성음료, 북서울꿈의숲 월영지 수질개선 맞손 [서울시 제공. 재판매 및 DB 금
- "안전 영웅 찾습니다"…'서울시 안전상' 후보자 추천 접수
- 연합뉴스 2025.07.21
- "안전 영웅 찾습니다"…'서울시 안전상' 후보자 추천 접수 [서울시 제공. 재판매 및 DB
- 서울신보-신한은행, '서울배달+땡겨요' 200억 특별보증
- 연합뉴스 2025.07.21
- 서울배달상생자금 신설해 이차보전·보증료 인하 등 혜택 서울시, 12개 소상공인 단체와 '서
- 대전 진잠초·대구 경서중·제주사대 부속중 '환경교육우수학교'
- 연합뉴스 2025.07.21
- 환경부 [연합뉴스TV 제공] (서울=연합뉴스) 이재영 기자 = 대전 진잠초등학교, 대구 경
- 1조 규모 ESS 정부입찰 이르면 금주 결론…승부처는 산업 기여도
- 연합뉴스 2025.07.21
- 새정부 국내 산업 육성 의지…非가격 배점 중 최대 비중 LFP LG엔솔·SK온 VS 삼원계
- 신세계百 센텀시티에 웹툰 '외모지상주의' 팝업
- 연합뉴스 2025.07.21
- 외모지상주의 팝업 [신세계백화점 제공] (서울=연합뉴스) 김윤구 기자 = 부산 해운대에 있
- 류진 회장 "韓 축소경제 심각…코어 근육 단력할 때"
- 이데일리 2025.07.21
- [서귀포=이데일리 조민정 기자] “인구가 감소하며 축소경제에 돌입한 것은 국가적으로 심각한

경기
임병택 시흥시장, 시민과 함께 시흥교육의 현재를 고민하고, 미래를 그리다
김기보 / 25.11.28

대전/세종/충남
대전시의회 김영삼 부의장 “특수영상의 성장, 새로운 기회 이끌어”
김영란 / 25.11.28

대전/세종/충남
세종시교육청, 영유아교육과 보육의 방향 논의를 위한 ‘비전 워크숍’ 운영
김영란 / 25.11.28